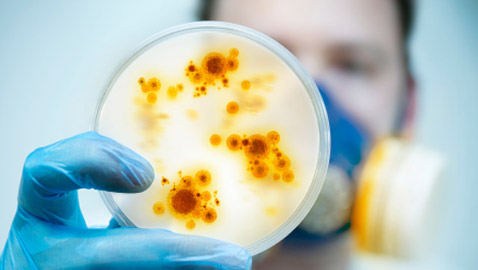
مكتشف مرض إيبولا يحذر العالم: أوبئة المستقبل ستكون كارثية أشد فتكا!

انت في زاوية "عالم المرأة"

لا شكَّ في أن السكر مادة أساسية بالحياة، للتفاصيل
اهلعوا، فإنّ الخبر أدناه والصور المرفقة للتفاصيل
عاشت البشرية عاماً كاملاً في ظل وباء للتفاصيل
تعتبر الكبة النية التركية أو كما للتفاصيل
لا شك في أن كثيراً من الناس يحبون للتفاصيل
في حين، يواصل العالم مكافحته لفيروس للتفاصيل
من هيفاء وهبي إلى نسرين طافش وراغب للتفاصيل
تناول الخبز لا يعني بالضرورة المزيد للتفاصيل
أوردت تقارير إعلامية أن سلالة كورونا للتفاصيل
يشكل ارتداء القناع مشكلة كبيرة لمن للتفاصيل

السابق
السابق للتواصل معنا
للتواصل معنا 